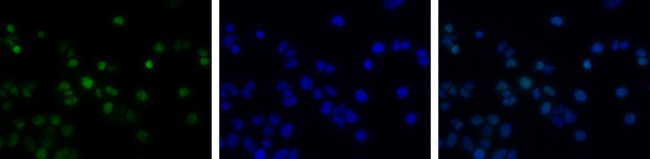
Phospho-Histone H2A.X (Ser139) Antibody in Immunocytochemistry (ICC/IF)

Search
Invitrogen
Phospho-Histone H2A.X (Ser139) Polyclonal Antibody
{{$productOrderCtrl.translations['antibody.pdp.commerceCard.promotion.promotions']}}
{{$productOrderCtrl.translations['antibody.pdp.commerceCard.promotion.viewpromo']}}
{{$productOrderCtrl.translations['antibody.pdp.commerceCard.promotion.promocode']}}: {{promo.promoCode}} {{promo.promoTitle}} {{promo.promoDescription}}. {{$productOrderCtrl.translations['antibody.pdp.commerceCard.promotion.learnmore']}}
图: 1 / 3
Phospho-Histone H2A.X (Ser139) Antibody (PA5-117754) in ICC/IF



产品信息
PA5-117754
种属反应
宿主/亚型
分类
类型
抗原
偶联物
形式
浓度
纯化类型
保存液
内含物
保存条件
运输条件
RRID
靶标信息
Histone H2A.X (H2AX) is a member of the histone H2A family which is one of the four core histones making up the nucleosome core particle. In eukaryotes, DNA double strand breaks (DSBs) have been shown to trigger the phosphorylation of serine 139 at the carboxy terminus of histone H2AX resulting in gamma-H2AX. The phosphorylation of H2AX can be detected by Western blotting or immunofluorescence, revealing the frequency of DSBs. The phosphatidylinositol 3-kinases have been implicated in H2AX phosphorylation, but it is unclear if ATM is the primary H2AX kinase or if other members of the family such as DNA-PK and ATR contribute in a similar manner. Structurally, H2A.x contains 143 amino acid residues. Histone H2A.X is considered a basal histone, being synthesized in G1 as well as in S-phase, and its mRNA contains polyA addition motifs and a polyA tail along with the conserved stem-loop and U7 binding sequences involved in the processing and stability of replication type histone mRNAs. There are two forms of Histone H2A.X mRNA, one about 1600 bases long and contains polyA; the other about 575 bases long, lacking polyA. The short form behaves as a replication type histone mRNA, while the longer behaves as a basal type histone mRNA. Histone H2A.X maps to the 11q23.2-q23.3 region of the human chromosome. Histone H2A.x contributes to histone-formation and therefore the structure of DNA. Histone H2A variant H2A.x specifically regulates the interaction of MDC1 (mediator of DNA damage checkpoint protein 1), a DNA repair protein to the sites of DNA damage.
仅用于科研。不用于诊断过程。未经明确授权不得转售。
篇参考文献 (0)
生物信息学
蛋白别名: gamma H2AX; H2A histone family, member X; H2a/x; H2AX histone; Histone H2A.X; Histone H2a/x; Histone H2AX
基因别名: H2A.X; H2A/X; H2AFX; H2AX
UniProt ID: (Human) P16104
Entrez Gene ID: (Human) 3014